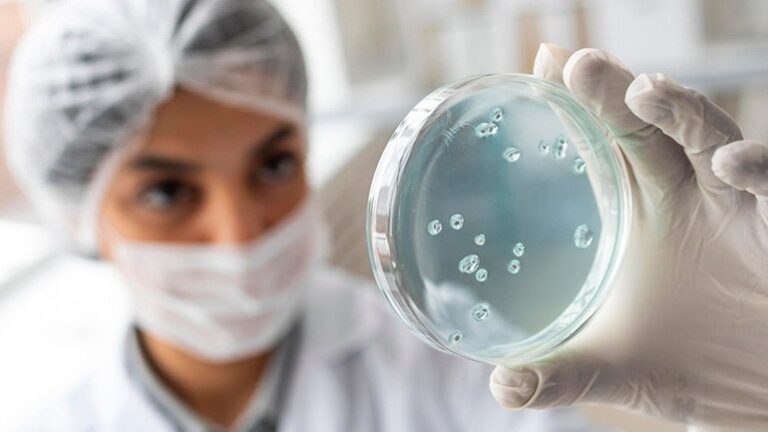

Представете си сценарий, в който собственото ви тяло не ви разпознава като свой приятел, а като враг и ви атакува
За съжаление, това не сюжет на научно-фантастичен филм, а реалност за милиони хора по света, страдащи от автоимунни заболявания.
Общото между тези състояния е, че имунната система, която обикновено защитава организма от външни заплахи, като вируси и бактерии, започва погрешно да атакува собствените клетки, тъкани и органи.
Автоимунните заболявания в наши дни не са рядкост. Статистиката показва, че по един или друг начин засягат между 5 и 10% от световното население, като по-често се срещат при жените.
И въпреки това, те често остават недиагностицирани или неразбрани. Причината е, че симптомите им могат да бъдат твърде неспецифични и да се припокриват с други състояния.
Какво представляват автоимунните заболявания
Както казахме, автоимунните заболявания са група състояния, при които имунната система грешно идентифицира част от тялото като чужда и започва да я атакува за да я унищожи.
Това може да доведе до възпаление, увреждане на тъканите и функционални нарушения в един или друг орган или система.
Най-често срещаните примери за автоимунни заболявания са множествената склероза, диабетът от тип 1, ревматоиден артрит, лупус, целиакия, псориазис, тиреоидит на Хашимото, Болест на Крон и много други.
При множествената склероза, например, имунната система атакува миелиновата обвивка на нервните клетки. При диабет тип 1, цел на имунната система е унищожаването на произвеждащите инсулин клетки в панкреаса.
Това са само малка част от примерите, но общото между тях е разрушителната сила на обърканата имунна система, която се превръща в неконтролируемо мощно оръжие.
Как функционира имунната система – и какво се обърква
В нормално състояние имунната система различава “своето” от “чуждото” чрез специфични рецептори и сложна комуникация между имунните клетки. Когато разпознае заплаха, тя активира защитни механизми, включващи възпаление и засилено производство на антитела и Т-клетки, които да унищожат натрапника.
При автоимунни заболявания тази система се дезориентира. Причината за това объркване не е напълно изяснена, но се предполага, че става дума за комбинация от генетична предразположеност и външни фактори.
Какво кара имунната система да атакува собственото тяло
Няма една конкретна причина, която да предизвиква тази аномалия, а по-скоро се касае за взаимодействие на различни рискови фактори.
Счита се, че някои хора носят гени, които ги правят по-податливи към едни или други автоимунни реакции. Така например, определени варианти на гена HLA се свързват с по-висок риск от ревматоиден артрит и целиакия.
В някои случаи вируси или бактерии също могат да предизвикат автоимунен отговор чрез така наречената молекулярна мимикрия, при която патогените имитират молекули от човешките клетки и така объркват имунната система.
Както вече споменахме, хормоните също оказват своето влияние. Жените например са по-засегнати от автоимунни заболявания, особено когато са в репродуктивна възраст, което говори за възможна роля на естрогена и някои други хормони.
Излагането на токсини, тежки метали, пестициди или хроничен стрес също е много важен фактор. До момента обаче не е съвсем ясно дали те, сами по себе си, могат да причинят автоимунно заболяване.
Това, което се знае със сигурност е, че тези фактори могат да засилят възпалителните процеси в организма, когато такива вече има.
Трябва да споменем и така наречената чревна дисбиоза, която представлява нарушение в баланса на чревната микрофлора. Това лесно може да компрометира чревната бариера и да доведат до така наречените “пропускливи черва”, което на свой ред засилва автоимунните реакции.
Какви са симптомите на автоимунните заболявания
Макар че всеки случай е индивидуален, има общи симптоми, които често присъстват при повечето автоимунни заболявания и такъв пример са хроничната умора и болките в ставите и мускулите.
При много автоимунни заболявания се появяват и кожни обриви или повишена чувствителност към различни външни влияния.
Храносмилателните проблеми, като газове, подуване и диария, също присъстват често. Други симптоми, които трябва да привлекат вниманието са подуване на жлези, повишена телесна температура и чести инфекции.
Разбира се, специфичните заболявания имат и свои характерни признаци, така че в никакъв случай не трябва да се очаква всичко изброено досега да се прояви едновременно.
Така например, при лупус може да се появи характерен “пеперудовиден” обрив по лицето, докато при множествената склероза се наблюдават зрителни нарушения и мускулна слабост.
Във всички случаи обаче ранната диагностика намалява риска от сериозни увреждания и води до чувствително подобряване на качеството на живот.
Лечение и управление на автоимунни заболявания
 В лечението на автоимунните заболявания няма универсално решение, което да излекува всеки проблем, а по-скоро се подхожда според конкретното заболяване и се прилагат стратегии за контролиране на симптомите.
В лечението на автоимунните заболявания няма универсално решение, което да излекува всеки проблем, а по-скоро се подхожда според конкретното заболяване и се прилагат стратегии за контролиране на симптомите.
Много важна роля тук играе прилагането на конвенционално лечение. Предписват се имуносупресори, като кортикостероиди и метотрексат, които потискат активността на имунната система.
След това се избират и подходящи противовъзпалителни лекарства, които да намалят болката и възпалението. В някои случаи се провеждат биологични терапии, които са насочени към конкретни молекули в имунната каскада.
В допълнение към основното лечение, много често се прибавят и алтернативни и холистични подходи. Обикновено се препоръчва противовъзпалителна диета с изключване на глутена, млечните продукти и рафинираната захар.
Включват се билки и добавки, като куркумин, омега-3, витамин D, цинк и пробиотици. Препоръчва се една или друга физическа активност, съобразена с индивидуалните възможности и състоянието.
Много често се предприемат и мерки, насочени към управлението на стреса, като например медитация, йога, техники за дишане и други. Индивидуалният подход е изключително важен, тъй като различните хора реагират по различен начин на терапиите.
Важно е да се осъзнае, че животът с автоимунно заболяване изисква приспособяване, но в никакъв случай не означава капитулация.
Поддържането на балансиран режим на хранене, редовна почивка, избягване на стреса и токсините, както и спазването на лечебния план, могат заедно значително да подобрят състоянието.
Не на последно място, важно е да се създаде подкрепяща среда от близки приятели и членове на семейството. Също така е полезно да се търси свързаност с други пациенти чрез пациентски групи, терапевти и други специалисти.